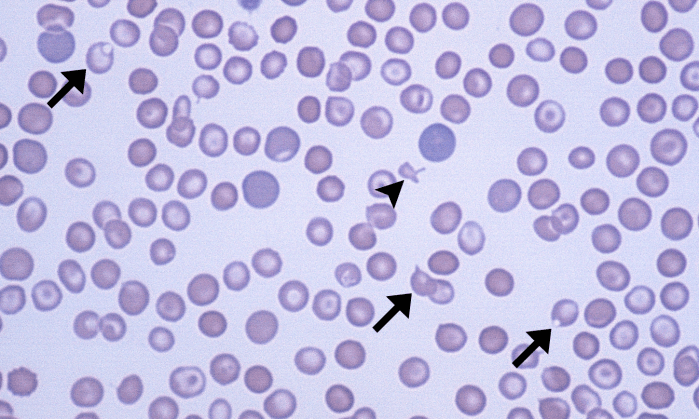
Keratocytes 4 (Canine 4 - DIC) ARROWS
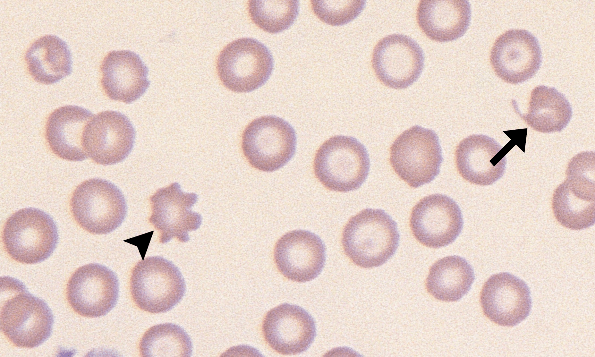
Keratocytes 6 (Canine 3 - Iron Deficiency) ARROWS

Keratocytes

Also called: blister cells (vesicle), helmet cells (ruptured)
Morphology: red blood cells with a blister-like vesicle on the margin, or a bite-shaped defect with horn-like projections on the margin (which results from rupture of vesicle).
Commonly seen with: schizocytes and acanthocytes (if caused by fragmentation injury), microcytosis and hypochromia (if caused by iron deficiency), eccentrocytes and Heinz bodies (if caused by oxidant injury)
Clinical relevance: indicates fragmentation injury to red blood cells related to vascular abnormalities (ie. disseminated intravascular coagulation, glomerular disease, vasculitis, hemangiosarcoma), mechanical fragility of red blood cells (ie. iron deficiency), or oxidant injury (ie. toxicity). May be associated with hepatic lipidosis in cats. Small numbers of keratocytes may be normal in healthy cats.